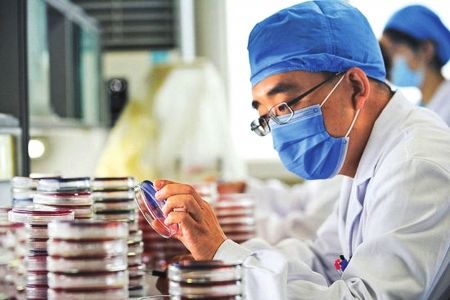

1.立即脱离中毒现场,脱去被污染的衣物、洗污染的皮肤及毛发,卧床休息,保持安静。严密观察并给予对症治疗。
2.纠正缺氧给予氧气吸入并保持呼吸道畅通。
3.防治肺水肿应早期、足量、短程应用糖皮质激素,控制液体输入量。可以应用消泡剂(二甲基硅油气雾剂)。4.预防感染、防治并发症、维持电解质平衡。
5.重度中毒者可予二乙基二硫代氨基甲酸钠(dithiocarb)口服,每次0.5g,每日4次,并同时服用等量碳酸氢钠,根据病情决定用天数,一般可连续服药3-7天。也可采用雾化吸入。
其他处理
轻度、中度中毒患者治愈后可恢复原工作。重度中毒患者经治疗后仍有明显症状者应酌情安排休养,并调离羰基镍作业。如需劳动能力鉴定,按GB/T16180处理。